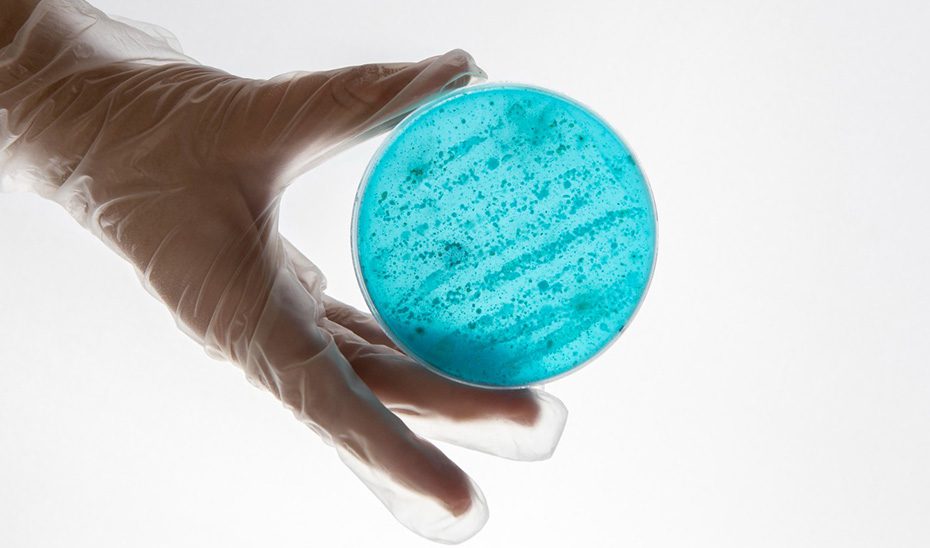
Andalucía intensifica las medidas frente al sarampión tras la detección de 47 casos

La Consejería de Salud y Consumo ha implementado nuevas medidas para reforzar el Protocolo de Vigilancia y Alerta del Sarampión tras la detección de 47 casos en Andalucía en lo que va de año, especialmente porque el contexto internacional de circulación activa del virus hace presagiar la importación de nuevos casos, pese a que la tasa de vacunación en la comunidad supera el 95% recomendado por la Organización Mundial de la Salud (OMS).
La Dirección General de Salud Pública y Ordenación Farmacéutica prepara un protocolo específico para tratar a los trabajadores agrícolas de la mano de la Consejería de Empleo, Empresa y Trabajo Autónomo, y uno para las personas en exclusión social, junto a la Consejería de Inclusión Social, Juventud, Familias e Igualdad y las ONG. Asimismo, acometerá campañas de vacunación en los municipios en los que se han detectado brotes, va a ofrecer formación específica a los profesionales sanitarios y cuenta con Salud Responde para llamar a los contactos de las personas con sarampión y ofrecerles una cita con enfermería, entre otras medidas.
Salud y Consumo también va a reforzar la coordinación con el sector privado para la declaración de los casos sospechosos y trabaja en la identificación de bolsas de personas susceptibles de contraer la enfermedad, especialmente por carecer de las dos dosis de la vacuna triple vírica, que es la que protege contra el sarampión.
De los 47 casos confirmados en Andalucía, ocho son menores de un año, que todavía no se han podido vacunar por su edad (la vacunación se administra actualmente en dos dosis, la primera a los 12 meses y la segunda a los 3 años). El 49% de los casos han sido menores de 15 años y el 51% adultos (entre 21 y 65 años). Sólo dos de estos casos tenían antecedente documentado de vacunación de una dosis, 24 casos no estaban vacunados y en 21 casos no se pudo conocer su situación vacunal (entre ellos menores procedentes de Marruecos o Rusia). El 47% de los casos ha precisado ingreso hospitalario.
El 26% de los casos han sido importados, procedentes de Marruecos (10), Bélgica (uno) y Dinamarca (uno). De los casos no importados, 11 son casos aislados en los que se desconoce la fuente de infección (cinco casos del municipio de Málaga, dos de Marbella, uno de Álora, uno de Calañas, uno de Huelva y uno de Palos de la Frontera).
En 2025 se han declarado hasta el momento actual seis brotes de sarampión confirmados de los que cinco siguen activos. El primero se detectó el 6 de febrero en una guardería de Fuengirola (Málaga), con 10 casos, todos relacionados con un caso importado y con una tasa de ataque en la clase de 0 a 12 meses del 50%.
El segundo de los brotes, declarado el 18 de 02, se produjo en un instituto de enseñanza secundaria de Mijas (Málaga) con seis casos, de fuente desconocida, con dos generaciones de casos, la primera en el propio centro y la segunda, familiar.
El 1 de marzo se declaró un brote de origen importado en Lepe (Huelva) cono cuatro casos, en trabajadoras marroquíes que llegaron a España el 10 de febrero.
En la escuela aviación en Málaga se declaró también un brote el 17 de marzo, con dos casos confirmados y un caso pendiente de confirmación. Y el quinto brote se declaró un día después, el 18 de marzo, con dos casos y uno pendiente de confirmación en una misma familia en Málaga.
Situación por provincias
Por provincias, Almería registra tres casos aislados (uno Roquetas de Mar, uno en El Ejido y uno en Adra); Granada ha declarado tres casos aislados; Huelva, 10 casos en total (dos en Gibraleón, tres en Palos de la Frontera, uno en Calañas, uno en Moguer, uno en San Bartolomé de la Torre, uno en San Juan del Puerto y uno en Huelva capital); 30 casos en Málaga (nueve en Fuengirola, nueve en Málaga capital, siete en Mijas, dos Marbella, uno en Álora, uno en Ojén, uno en Rincón de la Victoria) y uno en Sevilla capital.
En el caso de Málaga los casos se concentran principalmente en el Distrito Sanitario de Costa del Sol (19 casos).
Salud y Consumo recuerda, como confirman los datos registrados, que el sarampión es una infección que se transmite fácilmente, puede cursar grave y puede afectar tanto a niños como adultos no vacunados. Por este motivo, recomienda la vacunación de los menores en las pautas establecidas y de los adultos que no tengan constancia de estar vacunados para proteger a aquellas personas que no pueden vacunarse (los niños menores de 12 meses, que representan el 17% de los casos declarados en Andalucía).
La situación epidemiológica del entorno de Andalucía, especialmente Marruecos, que está experimentando un importante brote de sarampión desde octubre de 2023 y que se ha extendido por país con más de 40.000 casos notificados, incluidas 150 muertes; así como la presencia de bolsas susceptibles que pueden ser importantes en algunos distritos y la estacionalidad del sarampión (primavera), hace prever nuevos brotes en las próximas semanas y meses. La Consejería de Salud y Consumo ofrecerá un informe semanal los martes con los datos actualizados.